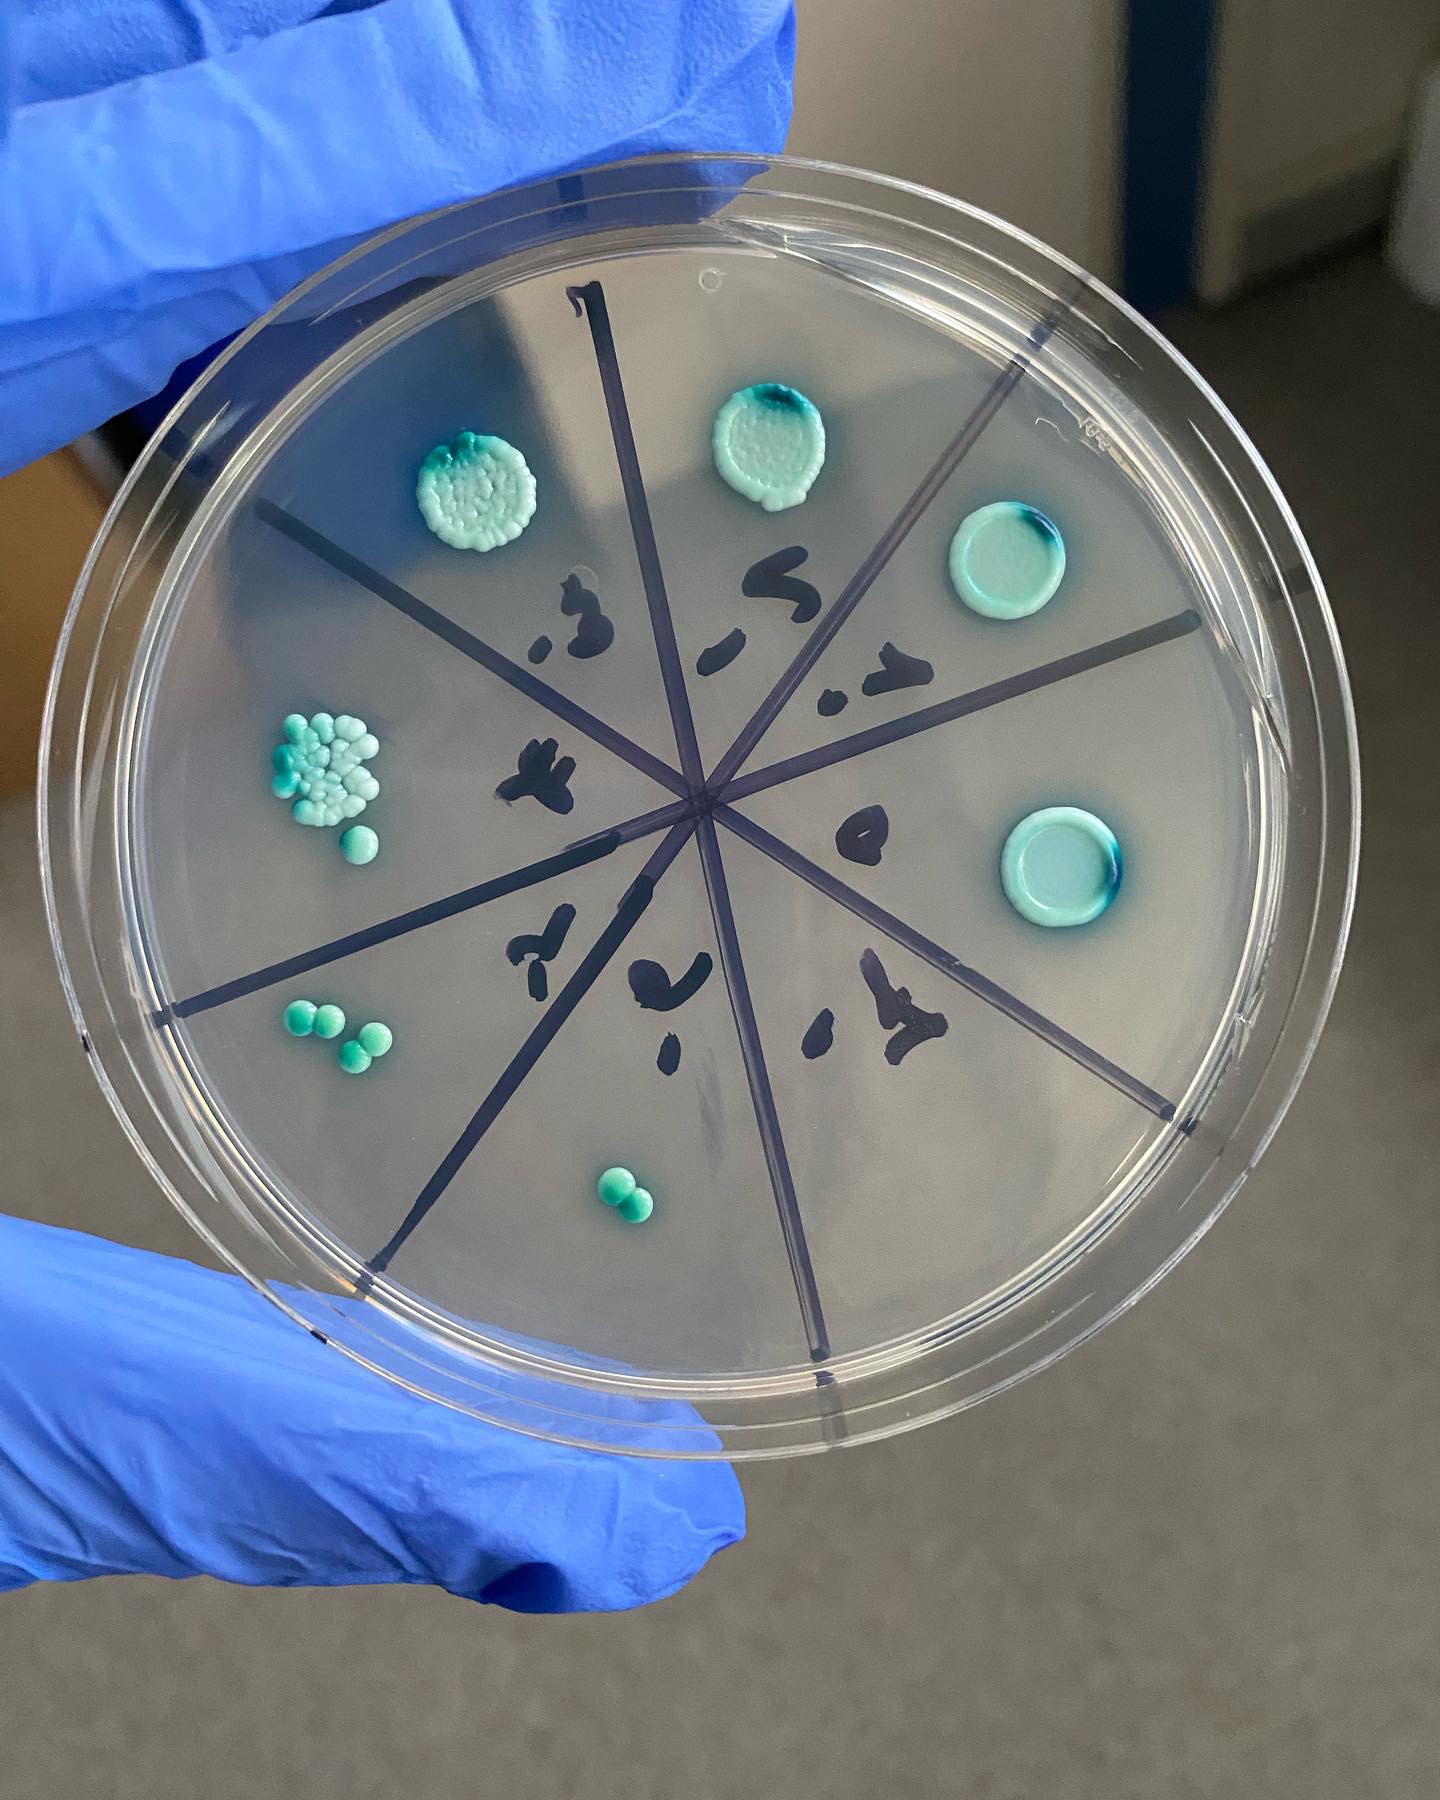
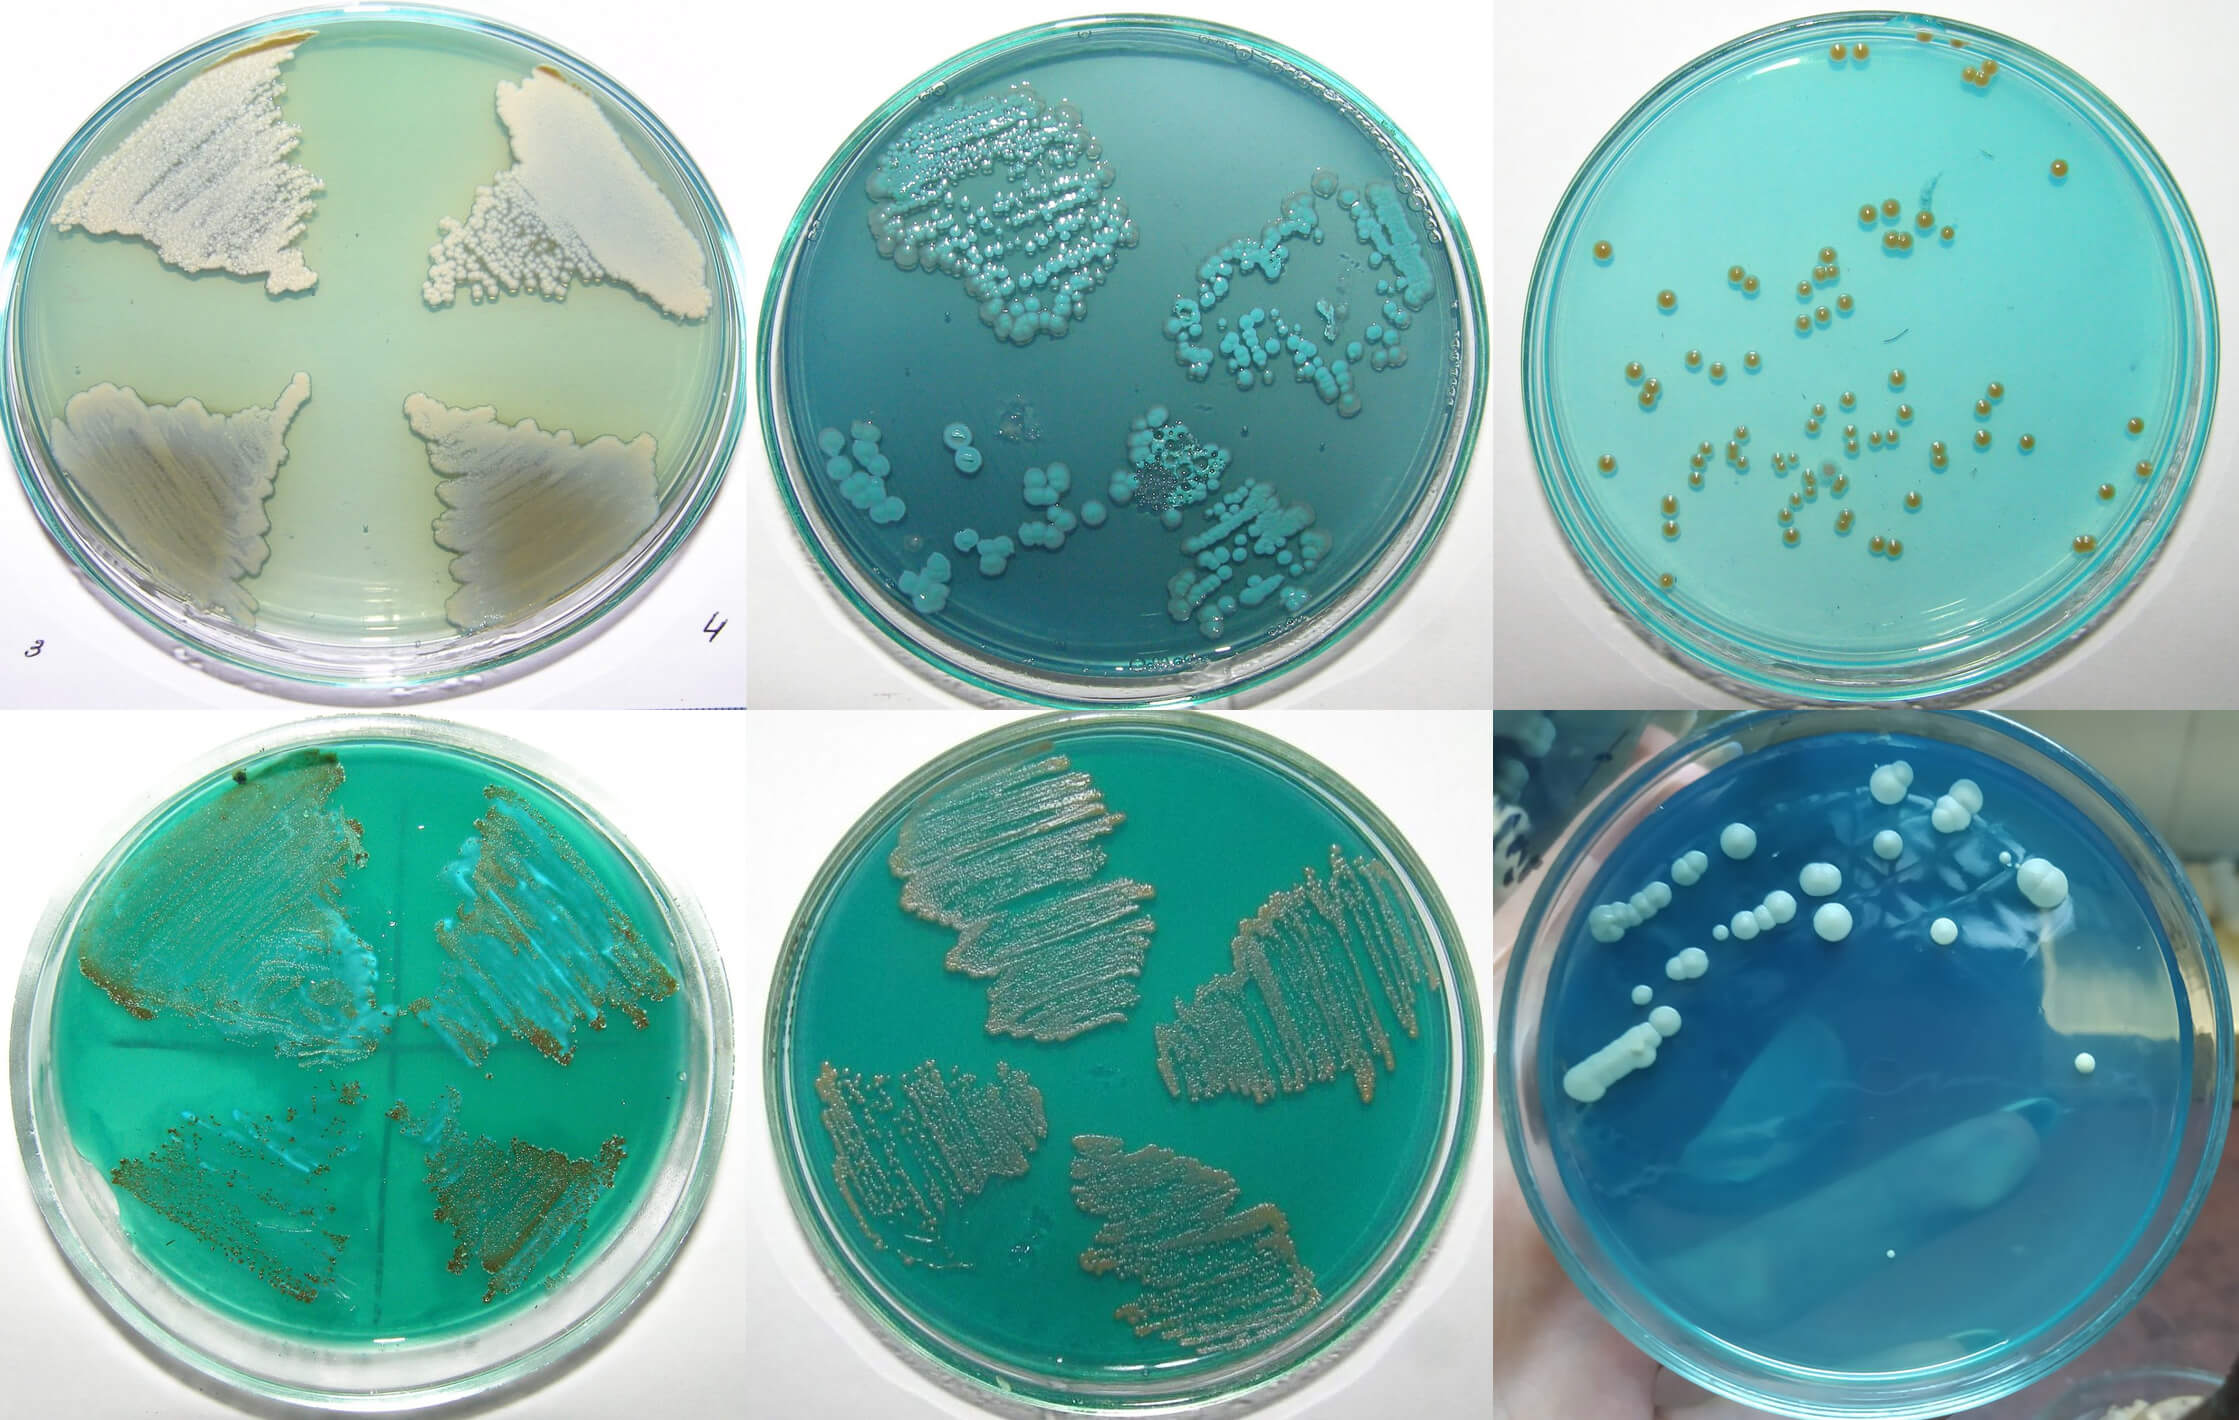

Важко знайти усміхненішу, оптимістичнішу й позитивнішу людину, ніж вона. Хоча її шлях не був устелений трояндовими пелюстками. Ентузіастка академічної мобільності, міжнародної та міжінституційної співпраці, молода, надзвичайно активна і продуктивна науковиця – все це про Олесю Гаврилюк, докторку філософії у галузі біології, наукову співробітницю відділу біології екстремофільних мікроорганізмів Інституту мікробіології і вірусології ім. Д.К. Заболотного НАН України і голову Ради молодих вчених цього Інституту. Торік вона разом зі ще двома науковицями Національної академії наук України отримала спеціальну відзнаку від журі української премії L’ORÉAL-ЮНЕСКО «Для жінок у науці» – за визначні успіхи у науковій кар’єрі. Про можливості переробки органічних відходів за допомогою бактерій, а також про особливості досліджень в Україні й за кордоном Олеся Гаврилюк охоче розповіла в інтерв’ю пресслужбі НАН України.

Докторка філософії Олеся Гаврилюк. Фото – з Facebook-сторінки науковиці
– Пані Олесю, розпочну з традиційного запитання: як Ви стали науковицею і хто Вас до цього спонукав, надихнув?
– Все почалось у дитинстві. Ще зовсім маленькою я хотіла стати ветеринарним лікарем. Потім – журналістом. А тоді мені випало взяти участь у кількох біологічних олімпіадах і конкурсах.
Я з Вінницької області, але щовихідних їздила до Вінниці у Малу академію юних натуралістів (це було відгалуження Малої академії наук). По суботах цікаві викладачі читали нам лекції з біології. Мені це дуже подобалося, досі згадую ті приємні часи. А раз на рік там відбувалися конкурси серед школярів. На один такий конкурс якось відрядили і мене. Але треба було вибрати тему і підготувати ґрунтовний виступ. Першими мені на думку спали бджоли. Бджіл тримав мій дідусь, а коли він помер (мені було тоді 5 років), комахами заопікувався мій тато. Це не було його хобі – він хотів зберегти бджіл у пам’ять про дідуся. Коли я підросла, залучав до цієї справи і мене. Я допомагала закладати вощину до вуликів, качала мед і навіть їздила продавати його на базарі. Тобто про бджіл я вже дещо знала, тому вирішила написати доповідь саме про них. Звісно, це важко назвати масштабною науковою роботою, бо школярі не виконують досліджень у повному розумінні цього слова. Але я була відмінниця і дуже старалася підготуватися добре. Написала 40 сторінок тексту включно з переліком літератури, підготувала презентацію. І виграла конкурс.
Потім мене відправили на ще один. Цього разу я взяла іншу тему. Моє рідне село Сестринівка на Вінничині було родинним гніздом Грушевських. Михайло Грушевський згадував його з великою теплотою, писав, що це чудова місцина. Й оскільки він кілька разів бував у Сестринівці, то тамтешні музей і парк носять його ім’я. Тому свою доповідь на другий біологічний конкурс я присвятила цьому парку і деревам, які там росли.
Словом, мені так сподобалося готувати конкурсні проєкти з біології та екології, вивчати джерела, долучатися до науки, бувати на різних заходах, знайомитися і спілкуватися з людьми, дізнаватися про їхні дослідження, що в 10-му класі я вже знала, куди вступатиму. Моєю мрією лишалася медицина, але я не дуже високо оцінювала свої шанси вступити на бюджет за цією спеціальністю. Крім того, ми з мамою тоді були вже вдвох – тато помер невдовзі по тому, як я виграла конкурс із доповіддю про бджіл, яку, до речі, він допомагав мені готувати. Але біологію кидати не хотілося, тому я вибрала те, що з нею пов’язане і що мені до душі, – біотехнологію. І вступила на факультет екологічної безпеки, інженерії та технологій Національного авіаційного університету [нині це Державний університет «Київський авіаційний інститут»], на кафедру біотехнологій.
– А як Ви потрапили до Інституту мікробіології і вірусології?
– Перший курс університету виявився переважно теоретичним, а мені подобалася практична наукова робота. Ми вивчали психологію, філософію, а от біології, мікробіології не вистачало. У перші місяці здавалося, що навіть у школі я виконувала більше досліджень. Викладачка мікробіології Лариса Сергіївна Ястремська [кандидатка сільськогосподарських наук, доцентка] познайомила нас з Олександром Борисовичем Таширевим [завідувач відділу біології екстремофільних мікроорганізмів Інституту мікробіології і вірусології ім. Д.К. Заболотного НАН України, доктор технічних наук, професор]. Йому тоді потрібні були перспективні студенти, які хочуть займатися наукою. І от 18-річною, по закінченні першого курсу, я вперше прийшла до Інституту, в лабораторію Олександра Борисовича. Він запитав, яка тема мене цікавить і чи серйозний мій інтерес. Я його запевнила, що приходитиму працювати після занять, робитиму все, що треба, тільки щоб навчитися. Бо в нашому університеті, звісно ж, теж були і лабораторії, і обладнання, але з дослідницькими можливостями Інституту їх не порівняти. Навіть попри те, що деяке інститутське обладнання було не найновіше. Олександр Борисович дозволив працювати у нього – під керівництвом Віри Михайлівни Говорухи [нині – старша наукова співробітниця відділу, кандидатка біологічних наук]. Вона саме закінчувала дисертацію про залізовідновлювальні мікроорганізми (це такі металорезистентні бактерії, які в довкіллі можуть трансформувати сполуки металів із токсичних у нетоксичні). Я ознайомилася з цією темою і почала працювати в команді з Вірою Михайлівною. Невдовзі ми вже опублікували першу спільну статтю. Бажання долучитися до справжньої науки було таким сильним, що я приходила в Інститут практично за будь-якої погоди. Пригадую, сніжить, морозно, на вулиці ожеледиця, а я після четвертої пари, яка закінчувалась о 15:30, їхала з Борщагівки у Феофанію. Добиратися було важко, та нас із подружкою-однокурсницею це не лякало. Мерзли, але їхали.

У відділі біології екстремофільних мікроорганізмів (2019 рік). Фото – з Facebook-сторінки Олександра Таширева

На «Днях науки – 2017» в Інституті мікробіології і вірусології ім. Д.К. Заболотного НАН України
– Наука вимагає жертв, так?
– Тоді було таке велике натхнення до роботи. Зараз думаю, що, можливо, це трохи занадто і варто ставитися до всього спокійніше.
– Це приходить з віком.
– Так. Іноді ж можна було присвятити трохи більше часу собі. Але я відчувала такий драйв, що йому не можна було опиратися. Хотілося постійно щось робити, рухатися вперед, дізнаватися нове. Ми з Олександром Борисовичем дуже часто працювали у лабораторії до пізнього вечора, майже до ночі. Наприклад, створювали дуже низький редокс-потенціал з металами (зокрема з ванадієм), тобто такий, за якого бактерії не можуть існувати, але у них виходило адаптуватись і до таких умов. Потім ми разом ішли на тролейбус. Думаю, оце натхнення до науки було великою мірою результатом впливу Олександра Борисовича, бо він і сам любить науку, й інших уміє зацікавити.

Олеся Гаврилюк і Олександр Таширев, 2017 рік. Фото – з Facebook-сторінки науковиці
Якось ми з Олександром Борисовичем і ще однією нашою колегою Марією Лободою, яка тоді була аспіранткою, а також зі знайомими спелеологами Олександра Борисовича спускались у глибини карстової печери Атлантида на Хмельниччині, відбирали зразки старовинних природних мікробних угруповань, які тисячоліттями розвивалися там, де не ступала людська нога (Олександр Борисович називав це біорозвідкою). Потім привозили ці зразки у лабораторію і досліджували їх: виділяли й ідентифікували нові штами, перевіряли їхню здатність детоксикувати метали. Оскільки мій тато помер, коли мені було лише 15 років, фігура наставника на тому етапі стала для мене надзвичайно важливою. Коли у 18 я вперше почала працювати у відділі Олександра Борисовича, він у багатьох аспектах замінив мені батька. Він завжди знаходив час, щоб дати пораду, підтримати або просто вислухати. Саме від нього мені передалося невгамовне бажання досліджувати, відкривати щось нове, залізти вглиб невідомого — як у прямому сенсі, під час спелеоекспедицій, так і в науковому пошуку. Він на своєму прикладі навчив мене не боятися складних викликів і завжди йти далі, шукаючи відповідей.

Олеся Гаврилюк і Олександр Таширев у печері Атлантида (2019 рік). Фото – з Facebook-сторінки Олександра Таширева

Там само. Фото – з особистого архіву Олесі Гаврилюк
В Олександра Борисовича взагалі багато знайомств і зв’язків по всьому світу. Він і в Антарктиді був. А якось 2019 року його запросили на конференцію в Литву, у Каунас, організатори оплатили квитки на літак. Але в таких випадках він ніколи не їздив сам, а намагався залучати всіх, хто активно працював разом з ним, щоб вони теж могли розповісти про свої дослідження. Того разу, наприклад, поїхали Віра Михайлівна і я.
Грошей на науку завжди бракувало, тому Олександр Борисович постійно шукав додаткові можливості, які підтримали б працівників відділу. Подавав заявки на ґранти. Скажімо, у 2018–2019 і 2020–2021 роках наш відділ виконував дослідження за ґрантами від CRDF Global (Фонду цивільних досліджень та розвитку США), до яких залучили і мене. Під час виконання проєкту за першим ґрантом я ще була 20-річною студенткою, а вже брала участь у такій серйозній роботі. Бо зазвичай брали старших науковців, щонайменше аспірантів, а студентів – рідше. Але тоді я цього не усвідомлювала – зрозуміла тільки пізніше.
Виконання проєкту в межах другого ґранту припало вже на мою аспірантуру. Наш відділ об’єднав цей ґрант зі ще одним – тревел-ґрантом від BioUkraine – і 2020 року ми з Вірою Михайлівною вирушили до США здобувати новий досвід. П’ять тижнів перебували в Університеті Південного Міссісіпі, працювали там з екологічно перспективними бактеріями – зі штамами роду Bacillus і з клостридіями, які здатні зброджувати великі обсяги органічних відходів. По-перше, відходів під час ферментації меншає. По-друге, в процесі мікробного зброджування виділяється біогаз. У цьому університеті ми познайомилися з новими людьми – й аспірантами, і вже досвідченішими дослідниками (з багатьма досі підтримуємо контакт, намагаємося співпрацювати), а ще – опанували сучасні методи лабораторних досліджень.
Наступні майже два тижні ми провели в Університеті штату Оклахома [факультет мікробіології та молекулярної біології], у лабораторії Маріанни Патраучан [докторка, професорка]. Вона теж з України і теж досліджує мікроорганізми, але псевдомонади (Pseudomonas), до яких належить, зокрема, синьогнійна паличка. Бактерії цієї групи впливають на регуляцію вмісту кальцію в клітинах інфікованого ними організму. В Університеті штату Оклахома для нас провели потужний вишкіл з молекулярної біології та біоінформатики, ознайомили з новітнім обладнанням – ампліфікаторами, апаратами для форезу (пізніше наш відділ придбав такі прилади за ґрантові кошти). Все нам показали й розказали.

В Університеті штату Оклахома (2020 рік). Фото – з Facebook-сторінки Олесі Гаврилюк
Ми були в такому захваті, повернулися з великим натхненням. І вдома теж почали застосовувати ці мікробіологічні й біохімічні методи, яких нас навчили американські колеги. Поєднали їх з молекулярною біологією. Такий підхід дає змогу виконувати дослідження на високому рівні і відкриває дорогу до опублікування у найкращих журналах.

У лабораторії докторки, професорки Маріанни Патраучан (перша ліворуч). У центрі – Віра Говоруха й Олеся Гаврилюк. Фото – з Facebook-сторінки Олесі Гаврилюк
– А що Ви досліджуєте саме зараз?
– Мої поточні наукові інтереси охоплюють екологічну та біомедичну мікробіологію. Останні два роки працюю в Іспанії і в Україні. Торік я працювала запрошеною дослідницею (visiting researcher) в Політехнічному університеті Каталонії за програмою іспанського уряду щодо підтримки українських науковців в Іспанії. Кілька місяців була там, потім поверталася на місяць додому. На початку 2025 року в мене було короткотермінове – чотиримісячне – стажування за тревел-ґрантом від FEBS (Федерації європейських біохімічних товариств). До середини травня я активно працювала над оптимізацією методів наноінкапсуляції біопестицидів для боротьби з фітопатогенними мікроорганізмами. Від 1 червня цього року я офіційно почала реалізувати власний науковий проєкт як постдокторська дослідниця в межах програми «Дії Марії Склодовської-Кюрі». Він триватиме два роки. Я подала заявку ще рік тому й щиро не очікувала, що отримаю фінансування, адже було подано понад 550 заявок, із яких лише 49 здобули підтримку. У галузі природничих наук пройшло не більше десяти проєктів, тому для мене це стало справжнім досягненням і великою честю. Моїм ментором став професор Цанко Цанов [керівник групи молекулярної та промислової біотехнології у відділі хімічної інженерії Політехнічного університету Каталонії]. Він болгарин за походженням, але вже 20 років працює в Іспанії. Разом з ним ми будемо розробляти наноструктури нового покоління для таргетного ураження респіраторних патогенів, зокрема Streptococcus pneumoniae. Оригінальна назва проєкту: «AntiMDR-NANO - Next-generation antimicrobial nanostructures to target multi-drug resistant respiratory pathogens» (HORIZON-1245103). Унікальність стипендії за програмою «Дії Марії Склодовської-Кюрі» полягає не лише у фінансуванні наукових досліджень, а й у всебічній підтримці кар’єрного розвитку дослідника. Програма передбачає вдосконалення лідерських навичок, участь у професійних тренінгах, курсах, воркшопах, опанування новітніх методик, а також вивчення мов. Такий підхід сприяє формуванню незалежних науковців із потужним міжнародним досвідом. Можливо, саме завдяки акценту програми на розвиток академічної автономії та лідерства професор Цанко Цанов довірив мені важливу роль — бути офіційним співкерівником дисертаційного дослідження аспірантки з Сербії Йовани Богдановіч (Jovana Bogdanovic). Це надзвичайно відповідальний і водночас надихаючий крок у моїй кар’єрі, адже раніше я мала досвід керівництва студентами бакалаврського та магістерського рівнів, але вперше виступаю у ролі співкерівника PhD-дисертації в іспанському університеті.
Я глибоко вдячна своєму науковому керівникові за цю довіру, яка відкриває нові горизонти для мого зростання як незалежного науковця. Для мене професор Цанов є прикладом справжнього, відданого своїй справі наставника та керівника, який поєднує серйозну наукову вимогливість із людяністю та щирою підтримкою.

Олеся Гаврилюк і аспірантка Йована Богдановіч на підпримстві з виготовлення вина у м. Турс (Франція) під час липневої зустрічі виконавців проєкту VINNY. Фото – з особистого архіву Олесі Гаврилюк
Раніше я їздила у закордонні лабораторії також у межах ґрантів від FEMS (Федерації європейських мікробіологічних товариств) та FEBS (Федерації європейських біохімічних товариств). До речі, ці два товариства надають чимало хороших ґрантів, але ними чомусь не всі користуються. Хоча українці зараз мають шанси виграти кошти на стажування, як, можливо, ніколи раніше. Особливо молодь. До початку повномасштабної війни ці ґранти теж надавались, але 2022 року FEBS і FEMS започаткували окремі ґрантові програми спеціально для українців. І деякі з цих програм існують досі. Є й інші ґранти, за які можуть змагатися громадяни різних країн, зокрема й українці. Це, наприклад, тревел-ґранти від Американського мікробіологічного товариства (American Society for Microbiology, ASM), Міжнародного комітету харчової мікробіології і гігієни (International Committee on Food Microbiology and Hygiene, ICFMH). Деякі колеги за кордоном ніби жартома кажуть, що Україна зараз має перевагу, бо у нас триває війна, і тому нас підтримують більше, цілеспрямовано. Я відповідаю: краще б цих переваг не було, але щоб не було і війни. До речі, ми і до великої війни успішно вигравали додаткове фінансування, в рівних умовах із науковцями з інших країн. Хоча, звісно, від 2022 року можливостей суттєво побільшало. У перший рік повномасштабного вторгнення підтримка взагалі була шалена. І багато ґрантів призначалися для вчених, які залишалися працювати в Україні. Один із них отримала і я – від польської Фундації імені Кшиштофа Скубішевського. Це був невеликий ґрант, але завдяки ньому можна було придбати реактиви і закінчити дослідження. Або дописати дисертацію чи наукову статтю.
Я не вважаю себе мотиваційним коучем, але хочу дати головну пораду молодим науковцям: поки ви молоді, маєте сили, натхнення і бажання – беріть участь у різних конкурсах, змагайтеся за ґранти, зокрема за тревел-ґранти, які допоможуть вам поїхати за кордон на стажування чи на конференцію. І для цього не конче кидати Україну та свою родину. Але академічна мобільність надзвичайно важлива: ви побачите світ, познайомитеся з новими людьми, лабораторіями, методиками, обладнанням, здобудете досвід, обміняєтесь ідеями. Це стимулює працювати краще. Потім усі ці знання й навички ви привезете додому, навчите студентів, які прийдуть до вас на практику. Саме тому тревел-ґранти круті. Здавалося б, що змінить у вашому житті тижнева поїздка на конгрес? Але це дуже мобілізує. Існує висока ймовірність зустріти там колег, з якими ви потім налагодите дуже предметну співпрацю: розподілите завдання, кожен виконає свою частину досліджень (а за кордоном зазвичай значно краще обладнання, ніж у нас) – і опублікуєте результати. Це надзвичайно важливо для науковців.
Ґрантодавці дуже часто оприлюднюють переліки з сотень лабораторій (з усіма контактами), які готові приймати аспірантів, студентів, навіть докторантів, постдоків. Для стажування можна обрати будь-яку з них – залежно від ваших зацікавлень і напряму досліджень. Навіть якщо ви не знайомі з керівниками і працівниками цих лабораторій – не бійтеся, пишіть їм e-mail’и. Інформація про більшість науковців, включно з відгуками, є в інтернеті. Розповідайте про себе, просіть листа підтримки, бо це обов’язкова умова для стажування: він засвідчує, що вас готові прийняти (забігаючи наперед, скажу, що по завершенні вам знадобиться лист-підтвердження про пройдене стажування). Будьте наполегливі, стукайте в усі двері. Хтось неодмінно відповість. Найбільше можливостей – до 35 років. Це роки навчання в аспірантурі і кілька років після захисту дисертації. Фондів, які надають ґранти, просто гать гати. Користуйтеся нагодою. Коли мені було лячно, колеги казали: «Пробуй, їдь». Дуже важливо, щоб вас підтримали. Я, наприклад, боялася їхати на ту-таки конференцію 2019 року в Литві, бо треба було доповідати англійською, а я почувалася невпевнено. Олександр Борисович радив попрактикуватись і таки виступити. Зрештою, все дійсно виявилося не так і страшно: більшість доповідачів не були native speakers, кожен говорив зі своїм акцентом. Так, у невідомість іти страшно. І важко, бо ситуація в країні депресивна. Легко не буде, мабуть, ніколи. Але це, навпаки, означає, що треба рухатися. Переборіть себе, намагайтеся перетнути те, що вважаєте межею своїх можливостей.

Науковці Інституту мікробіології і вірусології ім. Д.К. Заболотного НАН України на 9-ій міжнародній вайґлівській конференції (9th International Weigl Conference) у Жешувському університеті (Польща, 2024 рік). Фото – з Facebook-сторінки Олесі Гаврилюк
Отже, перша моя порада – пробувати себе. А друга – працювати в команді. Я помітила, що серед науковців є конкуренція. Не лише в Україні, а й за кордоном. Напевно, це взагалі така людська особливість. Але вона прийнятна і потрібна в розумних межах, коли ти, бачачи, що інші працюють краще, хочеш і сама навчитися, вміти більше, чогось досягати. Це здорова конкуренція. Але буває, що розум затьмарюється. Я не раз спостерігала таку ситуацію: коли у відділ приходить нова людина, яка, до того ж, серйозно ставиться до роботи, добре працює, здобуває собі репутацію, перспективи – дехто починає на неї косувати, уникати спілкування. Буває, просиш-просиш поділитися методикою, щоб виконати якесь дослідження зі своїми бактеріями, а тебе все годують обіцянками, що колись розкажуть. Приходиш раз, вдруге, втретє, а потім розумієш, що з тобою просто не хочуть мати справи, бо бачать у тобі конкурента. Іноді це назавжди. Зазвичай таке відбувається між однолітками. Що ж, це життя, але завжди можна знайти однодумців та людей для співпраці: вони поділяться з тобою, ти – з ними. Ви, знов-таки, об’єднаєтесь, виконаєте досліди, опублікуєте статтю. Win-win. Навіщо конкурувати? Робота має бути командна. Самому значно складніше досягти результату. Завдяки співпраці торік три мої статті у співавторстві вийшли друком у наукових журналах першого квартилю. Одна з них, яку опублікував журнал “Hydrogels MDPI”, стосується проєкту, який у 2023–2024 роках за ґрантом Національного фонду досліджень України виконували в Інституті молекулярної біології і геноміки НАН України під керівництвом Наталії Олексіївни Козировської [кандидатка біологічних наук, завідувачка лабораторії Інституту молекулярної біології і генетики НАН України]. Йдеться про створення гідрогелевих плівок для загоєння ран. Я була долучена до цього проєкту як виконавець, допомагала з деякими роботами. Друга стаття, присвячена наночастинкам Купруму, написана спільно з моїми іспанськими колегами, а керівник цього проєкту – завідувач нашої лабораторії в Іспанії професор Цанко Цанов. Третя стаття – в журналі “Biomedicine” – це результат співпраці з іспанськими та словацькими колегами. Ми досліджували як бактеріофаги здатні інгібувати утворення біоплівок патогенними мікроорганізмами. Тобто останнім часом, крім екологічних досліджень, виконую також біомедичні. Повторю ще раз: усе – завдяки командній роботі. У цьому – розвиток. Принаймні так говорить мій досвід.

З іспанськими колегами у лабораторії професора Цанко Цанова в Політехнічному університеті Каталонія. Фото – з Facebook-сторінки Олесі Гаврилюк
Коли я вперше приїхала до Іспанії за грантом FEMS, мені дуже допоміг доктор Леонардо Мартін Перес (Dr. Leonardo Martin Perez). Ми дійсно працювали як команда, підтримуючи одне одного: я займалася частиною експериментальної роботи, а він допомагав з оформленням результатів. Лео кілька років тому переїхав до Іспанії з Аргентини і певний час керував лабораторією санітарної мікробіології у відділі хімічної інженерії. Саме він познайомив мене з професором Цанко Цановим, під науковим керівництвом якого ми з Лео працюємо нині. Так живе науковий світ — через співпрацю, знайомства, обмін досвідом, зустрічі з різними людьми та спільну участь у проєктах. У науці все взаємопов’язано: хтось одного разу простягнув тобі руку допомоги — і згодом ти передаєш цю підтримку далі.

З доктором Леонардо Мартіном Пересом у лабораторії професора Цанко Цанова в Політехнічному університеті Каталонії. Фото – з особистого архіву Олесі Гаврилюк
– Даруйте за запитання: чи за кордоном не намагалися пропонувати Вам вигідніші умови роботи? Простіше кажучи, переманювати.
– Ні, ніхто ніколи мені не казав: «Кидай назавжди свій Інститут в Україні і переїжджай до нас». Кожен має вибір, ніхто нікого ні до чого не змушує. Зрештою, не обов’язково кидати щось одне, щоб починати щось інше. Можна працювати і тут, і там. Торік працювала в Іспанії як запрошений дослідник, тобто мала подвійну афіліацію – українську й іспанську. Запрошення до співпраці з-за кордону траплялись – у формі як проєктів, так і короткотермінових позицій. Зараз важливо зберігати наукові зв’язки з Україною, особливо в складні часи. Я бачу велику цінність у міжнародних партнерствах, але також вважаю за необхідне підтримувати українську науку, тому комбіную участь у міжнародних дослідженнях із роботою в українській інституції. Наприклад, умови використання ґрантів за програмою «Дії Марії Склодовської-Кюрі», на отримання яких я теж подавала заявки, навіть прописано так, щоб науковець не втрачав зв’язків зі своєю установою на батьківщині: до 30% тривалості закордонного стажування можна перебувати вдома. І це офіційно. Але зазвичай установи-господарі, які приймають дослідників з інших країн, не обмежують їхні візити на батьківщину щоразу, коли виникає необхідність (наприклад, для участі у дослідженнях, наукових заходах і не лише). Жодних проблем із цим немає, мені завжди йшли назустріч і ставилися з розумінням. Так само і в моєму українському Інституті: керівництво дає змогу працювати на дві країни. Крім того, це вигідно, бо допомагає налагоджувати міжнародні зв’язки, про що я вже сказала, а також підвищує рейтинг нашої установи завдяки спільним дослідженням і публікаціям (хоча зважають не тільки на це, а й на практичні впровадження). А від рейтингу залежить фінансування. Звісно, є й інші варіанти: дехто звільняється, емігрує, обриває контакти. Але, мені здається, в українських науковців, які тимчасово або постійно живуть і працюють за кордоном, має бути місія – максимально мобілізуватись і підтримати своїх колег в Україні.
– До речі, про впровадження. Й Олександр Борисович, і Віра Михайлівна дуже цікаво розповідали про розробки Вашого відділу. Чи доходять ці результати до практики? Або чи є бодай перспективи для їхнього широкого використання?
– Перспективи є. Вони завжди є. Але, звісно, впровадити розробку значно важче, ніж опублікувати статтю. Все залежить ще й від того, про яку країну йдеться: від фінансових можливостей, від попиту на ринку, від національного законодавства. Нещодавно Олександр Борисович і Віра Михайлівна разом із колегами з Інституту газу НАН України отримали Національну премію України імені Бориса Патона – саме за прикладні результати [з формулюванням «за роботу «Комплекси утилізації органічних відходів як елемент розподіленої генерації у воєнний час»»]. Це були багаторічні дослідження, пов’язані з біогазом. Створені установки-ферментери для переробки відходів успішно випробувано і на полігонах, і у приватних садибах, зокрема котеджних господарствах. Тобто розробка справді працює – і це підтверджено не просто в лабораторії, а на великих сміттєзвалищах. Але до масштабного промислового виробництва справа поки що не дійшла.

Олеся Гаврилюк, Олександр Таширев і ферментер. Фото – з Facebook-сторінки науковиці
– А виробники цікавляться вашими з колегами результатами?
– Цікавляться. Приїжджають, розпитують. Є й недобросовісні підприємці, які намагались отримати від нас конфіденційну інформацію або пропонували спершу використати розробку, а потім заплатити за неї – можливо, колись, якщо буде дохід. Але були в нас і господарські договори з виробниками. Наприклад, із фірмою з Волновахи. Ще до повномасштабної війни, 2019 року, вони застосували наші рекомендації, щоб оптимізувати синтез біометану за допомогою мікробного зброджування органічних відходів, збудували у себе величезні ферментери, були дуже задоволені, підготували для нашого Інституту офіційний звіт про впровадження. Тобто не все так безнадійно було і є.
Наталія Олексіївна Козировська з Інституту молекулярної біології і генетики, про яку я вже згадувала, теж співпрацює з фірмами, які виготовляють гідрогелеві пов’язки, і цю розробку нарешті планують виробляти на продаж, бо це важливо, зокрема, для військових. Запаковані гідрогелеві патчі вже передавали на фронт, їхню здатність пришвидшувати загоєння ран і вбивати різні супутні інфекції підтверджено.
Але, наскільки мені відомо, загалом у практику потрапляють лише кілька відсотків дослідницьких результатів. Тобто є прогалина між наукою і промисловістю. Не лише в Україні – скрізь. І це проблема. За кордоном постійно відбуваються якісь форуми, де науковці і підприємці збираються, щоб познайомитись і обговорити можливу співпрацю. Такі заходи проводять, щоб стимулювати впровадження розробок. На одному з цих форумів – у Барселоні – нещодавно побував і керівник нашої іспанської лабораторії. Повернувшись, він розповідав, про що говорили учасники. Передусім про причини розриву між дослідженням і виробництвом. Вони – об’єктивні і зумовлені специфікою цих двох сфер діяльності. Інженер, технолог, дослідник на підприємстві теж може мати цікаві наукові результати, але вони не виходять за стіни його компанії. Він не пише наукових статей, не працює зі студентами, а сконцентрований тільки на практичному ефекті. Якщо технологія працює (наприклад, бактерія синтезує вітамін) – для виробництва цього досить. Люди виготовляють продукт, продають його, заробляють гроші – і все. Це характерно, скажімо, для харчової промисловості, косметичних компаній. Клінічних випробувань там мінімум. Креми, які позиціонуються, умовно кажучи, як «природні матеріали з рослин, які вирощувала прабабуся» можуть продавати взагалі без жодних сертифікатів. А от із біомедичними розробками все значно серйозніше. Щоб отримати дозвіл на виробництво і продаж тих-таки гідрогелевих патчів або лікарських препаратів, або кремів від псоріазу, потрібні масштабні клінічні дослідження. А це величезні кошти і роки, а то й десятиліття роботи. Майже нереально.
Професор Цанко Цанов має зареєстрований патент і досвід продажу наночастинок для різних застосувань, зокрема як основи для інкапсулювання різних біологічно активних сполук, антибіотиків, біодобрив та біопестицидів. Але є у нього і власні медичні розробки. Одна з них — спеціальні наночастинки для обробки сечовивідних катетерів задля запобігання формуванню біоплівок. Це потрібна річ, бо пацієнти, які користуються катетерами, часто страждають від супровідних інфекцій, особливо бактеріальних. Наприклад, дуже небезпечною є уропатогенна кишкова паличка: якщо звичайна кишкова паличка може бути нешкідливою, то її уропатогенний штам резистентний до антибіотиків. Так от, у відділі професора Цанова розробили біосумісний і безпечний антимікробний розчин, яким можна обробляти пластикові матеріали, зокрема катетери, щоб патогенні мікроорганізми не формували біоплівок. Тобто, фактично, запобігає проблемі антибіотикорезистетності в цьому конкретному випадку. Позитивний результат, до речі, підтвердили тести у шпиталях, але розробка досі не впроваджена, хоча її створили завдяки програмі «Горизонт Європа». Бо потрібні дуже великі кошти і великі зусилля для багатоетапних клінічних досліджень.
Розрив між наукою і виробництвом із боку науки має ще один нюанс: головне завдання науковця – виконувати дослідження. На Заході до цього додається ще й обов’язок викладати, бо лабораторії діють переважно в університетах. Типова наукова кар’єра там виглядає так: здобув освіту, захистив дисертацію, провів кілька років у постдокторальних дослідженнях, а далі маєш готувати наступні покоління вчених. Ну, і, звісно, продовжувати дослідження і публікувати статті. Поєднувати це все ще зі впровадженням розробок на виробництві практично неможливо.

У лабораторії Університету штату Оклахома. Фото – з Facebook-сторінки Олесі Гаврилюк
Усіх науковців спонукають: публікуйтесь, публікуйтесь, публікуйтесь. І стимулюють публікаційну активність. Розповім, як це відбувається у Словаччині, бо закордонним науковим керівником дисертації, яку я захистила 2022 року, був Руслан Тарасович Марійчук – український хімік, який уже 15 років завідує кафедрою екології в Пряшівському університеті, а познайомилися ми, до речі, 2019 року на конференції у Каунасі, і відтоді співпрацюємо (моїм українським науковим керівником була Віра Михайлівна Говоруха). Під час навчання в аспірантурі я мала нагоду стажуватися в його лабораторії завдяки Вишеградській стипендіальній програмі. Так от, Пряшівський університет отримує від держави суттєве додаткове фінансування за кожну статтю, опубліковану у рейтинговому фаховому журналі першого квартилю. Причому ці кошти дають змогу покривати робочі витрати не лише самого автора статті, а й інших працівників університету. Що більше таких статей, то більше фінансування. І всі тільки виграють від цього. Це дуже мотивує.
Річ у тім, що мало виконати дослідження і написати статтю, – ще треба знайти кошти, щоб її опублікувати. Дешевше зробити це в журналах із закритим доступом. Але якщо ти хочеш, щоб із твоїми результатами ознайомилася ширша аудиторія, доведеться заплатити. Інколи ціни варіюються у межах від двох до п’яти тисяч доларів США. Тому за кордоном чимало організацій надають науковцям ґранти, які передбачають витрати зокрема або виключно на опублікування статей. В Україні ж науковці намагаюся максимально витратити кошти на реактиви й обладнання. А щоб опублікуватися, кооперуємося з іноземними колегами, в яких більше фінансових можливостей. Взагалі наша робота пов’язана з тим, що потрібно постійно багато писати. Коли ти аспірант, то більшість часу проводиш у лабораторії – це близько 80% твоєї роботи. Після захисту дисертації акцент зміщується на написання публікацій і звітів, на підготовку заявок для ґрантових конкурсів. Багато науковців ще й рецензують статті колег.

За роботою. Фото – з Facebook-сторінки Олесі Гаврилюк
Але оця жорстка настанова публікуватися більше, частіше, у кращих журналах має зворотний бік – вона спонукає деяких авторів оприлюднювати неправдоподібні дані. Тобто кількість публікацій зростає, але їхня якість може погіршуватися. Буває, читаєш статтю хочеш використати описаний у ній метод, а не виходить, не працює. Пробуєш і так, і так, а потім розумієш, що це, напевно, просто якась дурня. Неякісні за суттю статті іноді важко відрізнити, бо вони добре написані, але містять спотворені результати. Якусь інформацію автори можуть приховувати навмисно, щоб нею не змогли скористатись інші дослідники. Тому, я думаю, хай краще у мене буде одна-дві статті на рік, але якісні. Бо коли від тебе вимагають публікувати 5 статей на рік і зважають, яким ти є автором – першим чи останнім, то це не про власне науку, це вже якісь перегони.
– Тут, мабуть, важко змагатися з китайцями.
– У них, звісно, є хороші статті. Але іноді читаєш і розумієш: китайські науковці роблять акцент на тому, що вони зробили, а не навіщо. У них дуже багато дорогих приладів і вдосталь витратних матеріалів. Але деякі дослідження можна було виконати значно простішими методами.
– Частина ваших із колегами досліджень, як Ви вже розповідали, стосуються переробки відходів. Здавалося б, це дуже актуальна і болюча тема, бо людство продукує сміття такими обсягами, що ризикує в ньому потонути. Але, схоже, до цієї проблеми замало уваги і більшість із нас усе ще не сортують відходи.
– Так, на жаль, небагато людей займається сортуванням відходів. І ще менше — використовують сучасні технології для їх утилізації. Насамперед ідеться про органічні, харчові відходи: їх можна змішати та піддати мікробному зброджуванню — і вже за 2–3 дні на виході отримати біогаз і ферментований рідкий залишок, адже органіка є джерелом вуглецю. Крім того, під дією ферментативних систем бактерій деякі полімери трансформуються до мономерів, наприклад глюкози, яку мікроорганізми надалі використовують як джерело енергії.
Неорганічні матеріали загалом складніше піддаються біодеградації. Наприклад, металеві пакувальні контейнери (жерстяні банки) можуть зберігатися в довкіллі десятиліттями, суттєво не розкладаючись. Хоча поліетилен і пластик певні бактеріальні штами вже здатні частково руйнувати, цей процес є повільним і неефективним у природних умовах. Пластик — це, безумовно, екологічна проблема. Хоча правильніше сказати, що проблема полягає не стільки в самому матеріалі, скільки в людському чиннику – у неналежній утилізації. Адже пластик від початку був задуманий як багаторазовий матеріал, що мав замінити пакувальні вироби, які при біорозкладі на сміттєзвалищах забруднювали довкілля.
– Яка іронія! А тепер усі знову переходять на торби. Екоторби, як їх називають.
– Так. Бо замість того, щоб ощадливо використовувати пластик, його масово викидають. Ще одна величезна проблема, похідна від цієї, – мікро- і нанопластик. Це мікрочастинки пластику. Зараз уже немає такого середовища, в якому їх не було б. Вони токсичні, накопичуються в рослинах, у воді і впливають на наше здоров’я. Наразі з цим важко щось вдіяти. Потрібно бодай почати відокремлювати органічні відходи від неорганічних і переробляти їх. Олександр Борисович проєктував наші ферментери з думкою про приватні господарства, котеджі, які могли б забезпечувати себе біогазом самі. І деякі користувачі випробували цю розробку, але масштабувати її поки що не вдається.
– А ви з колегами її якось рекламуєте?
– В Олександра Борисовича є YouTube-канал, де він викладає сюжети про розробки нашого відділу. Публікує інформацію в соцмережах, зокрема у своєму Facebook-профілі. 2020 року разом з Олександром Борисовичем і Вірою Михайлівною ми брали участь у навчальній програмі GIST Innovates Ukraine. Це щось на зразок курсів для стартаперів-початківців. Нас навчали, як аналізувати ринок і як правильно просувати розробки. Ми, наприклад, брали інтерв’ю в потенційних споживачів. Вивчали громадську думку, так би мовити. Відгуки про нашу розробку були різні: хтось зацікавився, а хтось відповів, що для нього це не підходить, бо незручно. Річ у тім, що наш ферментер доволі габаритний. Це добре для приватних садиб і ферм, які продукують багато відходів. Але у квартирах ніхто не хоче ставити таку велику установку. Якщо власники й вирішують якось переробляти органіку, то встановлюють зменшений аналог механічного подрібнювача. Його вмонтовують у водяний стік на кухні, де зазвичай миють і чистять городину. Тобто мешканцям потрібно буде тільки відсортувати неорганічні відходи – пластик, метал, – а овочі і решту органіки, яка може гнити, просто вкидають у подрібнювач і натискають кнопку. Харчові відходи за кілька секунд перемелюються і зливаються у стоки, тобто в підземні води. Це не розв’язує проблему остаточно, бо ми все одно забруднюємо довкілля. У цьому випадку – токсичним фільтратом, з якого теж можна було б отримати біогаз. Але цей фільтрат значно менш небезпечний за тверді органічні відходи, які постійно накопичуються, а розкладаються дуже довго, роками. І оцій серйозній проблемі ми й намагаємося дати раду.
– Як мотивувати людей сортувати сміття і по змозі користуватися спеціальними установками для переробки того, що можна переробити вдома?
– Це складне питання. Важко мотивувати людей самими поясненнями, що сортувати і переробляти сміття важливо для збереження довкілля. Потрібні серйозніші аргументи. І до того ж – на державному рівні.
Напевно, мають бути законодавчі стимули. Якщо люди можуть не витрачати на щось кошти, то вони зазвичай так і роблять. Тому, скажімо, слід закладати у вартість пластикового пакету витрати на його переробку. Можливо, пропонувати якусь вигоду, заохочення, зручність. Збільшувати кількість пунктів, які збирають специфічні відходи, наприклад батарейки. Бо зараз це роблять переважно великі торговельні мережі.
А з того, що найочевидніше, – ставити окремі контейнери для різних видів відходів. В Іспанії обов’язок сортувати відходи існує, але він доволі формальний, бо за його дотриманням ніхто не наглядає. Зате практично на кожному кроці стоять кольорові контейнери для роздільного збору сміття: один – для органіки, тобто харчових відходів, а простіше кажучи – для всього, що гниє; один – для пластику (пакетів, стаканчиків тощо); по одному – для паперу, скла й металу. Це психологічно стимулює сортувати сміття. І це те, що не потребує великих зусиль.
Крім того, треба інформувати, навчати. Пояснювати, що, наприклад, пластик, забруднений органікою, до переробки не надається, тому перш ніж викинути стаканчик з-під йогурта, його потрібно помити і висушити.
У моєму оточенні більшість людей сортує відходи. Але, звісно, є люди, яких ніяк не змотивуєш, – тільки штрафами.
Тобто варіанти можуть бути різні.

У лабораторії. Фото – з Facebook-сторінки Олесі Гаврилюк
– Пані Олесю, а розкажіть, будь ласка, про свої найцікавіші наукові результати. І про те, що Ви хотіли б досліджувати надалі.
– Я обожнюю свою тему – екологічну мікробіологію. Працюю з мікроорганізмами роду Pseudomonas, уже маю чимало результатів щодо бактерій, здатних трансформувати метали. Застосовуючи методи біоінформатики, аналізую геноми і потенціал цих бактерій. Це велика теоретична робота.
Ще один напрям – прикладний – екологічна біотехнологія. Наприклад, у проєкті за ґрантом Національної академії наук України для молодіжних дослідницьких лабораторій і груп (ним керує моя колега і подруга Марія Лобода [докторка філософії, наукова співробітниця відділу загальної та ґрунтової мікробіології Інституту мікробіології і вірусології ім. Д.К. Заболотного НАН України]) я працюю над створенням мікробного препарату (ми називаємо його мікробним фітосорбентом) для очищення і поліпшення якості ґрунтів, пошкоджених воєнними діями, зокрема забруднених металами. Україна потребуватиме цієї розробки ще десятками років. Війна триває, але коли вона закінчиться, мусимо вже мати дієві технології.
– Ці дослідження пов’язані з дослідженнями Людмили Олексіївни Білявської? Чи вони паралельні? [Людмила Білявська (1978–2025) – українська науковиця-мікробіологиня, докторка біологічних наук, завідувала відділом загальної та ґрунтової мікробіології Інституту мікробіології і вірусології ім. Д.К. Заболотного НАН України у 2021–2025 роках (зараз обов’язки завідувача відділу тимчасово виконує кандидатка біологічних наук, доцентка Тетяна Рожкова); останнім часом шукала оптимальних методів регенерації ґрунтів і спільно з колегами запропонувала, зокрема, біотехнологію відновлення ґрунтів, понівечених війною.]
– Ні, це паралельні дослідження, але до молодіжної дослідницької групи увійшли науковці обох наших відділів – відділу загальної та ґрунтової мікробіології (Марія Лобода) і відділу біології екстремофільних мікроорганізмів (аспірантка Ірина Біда і я). Бо ми маємо спільну тематику – це екологічна мікробіологія, зокрема ремедіація, тому точки дотику знайти було неважко. І в цьому проєкті за академічним ґрантом ми доповнюємо одні одних. У відділі загальної та ґрунтової мікробіології вивчають стрептоміцети – корисні бактерії, більшість з яких не продукує жодних токсинів. Але колеги зосередилися на біосинтетичних властивостях стрептоміцетів і мало досліджували їхню стійкість до металів, їхню здатність ці метали трансформувати. У нашому ж відділі, навпаки, вивчають різні природні мікробні угруповання, здатні детоксикувати метали. Це потрібно для того, щоб іммобілізувати метали, переводити їх у нерозчинні форми, бо у розчинній формі вони токсичні. Крім того, наші бактерії можуть продукувати різні фітогормони, стимулювати ріст рослин.
Дріжджоподібні гриби виду Candida albicans (кандіда біліюча) на селективному агарі й із хромогенною сумішшю у складі. Фото – з Facebook-сторінки Олесі Гаврилюк
Проєкт розрахований на два роки – 2024-й і 2025-й. Торік ми відібрали штами бактерій родів Pseudomonas, Bacillus і Streptomyces, що мають найбільший потенціал для відновлення ґрунтів. Тобто вони здатні і детоксикувати метали, і продукувати певні антагоністичні речовини для інгібування (пригнічення) росту фітопатогенних грибів у ґрунтах, які зазнали впливу війни. Ці ґрунти не просто пошкоджені й забруднені – у таких-от несприятливих умовах розвиваються різні патогенні грибки й бактерії, які не лише можуть бути шкідливими для рослин і здоров’я людини, а ще й стійкі до екстремальних чинників. Отже, потрібно спершу стабілізувати мікробіом ґрунту корисними бактеріями. Зараз ми досліджуємо – якими саме. Вже відібрали перспективні штами, виконуємо дослідження in vitro, працюємо над мікробним препаратом. Плануємо перевірити його ефективність у лабораторних умовах, щоб з’ясувати, як рослини на нього реагують.
Мене цікавить іще одна тема, пов’язана з екологічною біотехнологією та екологічною мікробіологією, – розроблення нанобіопестицидів. Як я вже говорила, для цих досліджень я виграла короткотерміновий ґрант (на 4 місяці) від Федерації європейських біохімічних товариств. Нанобіопестициди – це речовини, які теж здатні інгібувати ріст фітопатогенних грибів і бактерій, поліпшувати ріст рослин, мають антимікробні властивості, а водночас не містять токсичних сполук, зокрема металів. Як нанобіопестициди можна застосовувати фенольні сполуки (галову кислоту, рутин, кверцитин), флавоноїди. Їхні антимікробні властивості, звісно, не такі сильні, як у срібла, міді чи мідного купоросу, але вони спроможні контролювати ріст і розвиток мікроорганізмів, серед іншого й патогенних, які мене цікавлять передусім. Йдеться про інкапсуляцію біопестицидів із використанням інертних матеріалів, таких як лігнін, що слугує матрицею для контрольованого вивільнення діючих речовин. У живій деревині лігнін містить природні фенольні сполуки, але після переробки втрачає їх і стає нейтральним. Та завдяки лабораторним методам нанобіотехнології його можна знов активувати. Нейтральний лігнін, насичений фенольними групами, набуває антимікробних властивостей. У межах цього короткотермінового ґранту я досліджувала методи інкапсулювання антимікробних сполук природного походження, щоб контролювати і пригнічувати такі фітопатогени, як гриби Penicillum expansum, Botrytis cinerea і бактерії виду Rizobacterium vitis. Ці дослідження можуть стати основою для створення ефективних препаратів, які одночасно стимулюватимуть ріст рослин і контролюватимуть розвиток фітопатогенів. Крім того, цей проєкт є логічним продовженням і доповненням до наших із колегами досліджень, які виконуються в межах молодіжного ґранту НАН України, та може стати практичною основою для розроблення біотехнологічних рішень, спрямованих на подолання екологічних наслідків воєнних дій, зменшення рівня забруднення довкілля й відновлення родючості виснажених українських ґрунтів.
Купрумрезистентні штами бактерій родів Bacillus і Pseudomonas. Перспективні кандидати для розроблення біотехнологій очищення купрумвмісних водойм і ґрунтів, а також для вилучення купруму з природних мінералів і гірських порід (можуть бути використані у гірничо-видобувній промисловості)
Я вже розповіла, що спробувала себе у біомедичних дослідженнях, коли у команді Наталії Олексіївни Козировської брала участь у дослідженнях гідрогелів. Так склалося, що я продовжую працювати у групі молекулярної та промислової біотехнології (GBMI) у Політехнічному університеті Каталонії, де також займаються розробкою гідрогелів, наноматеріалів, систем доставки антимікробних сполук тощо. Ця тематика дуже близька до досліджень Наталії Олексіївни. Професор Цанко Цанов, мій іспанський керівник, за фахом хімічний інженер, але у відділі, який він очолює, є чимало можливостей для біомедицини. Одна з найгостріших проблем у світі – це резистентність бактерій до антибіотиків, а також до металів та інших токсичних речовин. Іноді її долають поєднанням кількох антибіотиків. Але дуже складно знайти сполуку, що вбиває конкретну бактерію – скажімо, синьогнійну паличку (Pseudomonas aeruginosa) чи золотистого стафілокока (Staphylococcus aureus). Мова йде про таргетне ураження специфічного штаму мікроорганізмів. Крім того, значну небезпеку становлять мультирезистентні патогенні штами. Щоб припинити поширення стійких до різних антимікробних сполук бактеріальних інфекцій у шпиталях і поза ними, потрібні нові альтернативні методики і препарати, здатні подолати мультирезистентність, тобто опірність мікробів до багатьох антимікробних сполук одночасно. Деякі препарати вже застосовуються у терапії, однак це досі гаряча тема, що потребує подальших досліджень. Мене ця тема теж дуже цікавить, і я вже почала її вивчати. Вважаю перспективною таргетну терапію. Хотіла б розробляти препарати, які вбиватимуть патогенні штами, але не шкодитимуть корисним мікроорганізмам і не руйнуватимуть імунітет пацієнтів. Щодо цього є різні ідеї. Один із варіантів – застосування антитіл, коли за основу беруть реакцію «антиген–антитіло». Як це може виглядати? Відомо, що бактерія виробляє білок, життєво необхідний для її розвитку та формування біоплівки — структурованої колонії клітин, у якій бактерії об’єднуються для підвищення виживаності та захисту від несприятливих чинників середовища. Важливу роль у цьому процесі відіграє кворум-сенсинг (quorum sensing) — система клітинної комунікації, що дає змогу бактеріям координувати свою поведінку залежно від кількості особин у популяції. Застосування речовин, які інгібують кворум-сенсинг, відкриває перспективи для контролю патогенних бактерій без необхідності знищення клітин — шляхом порушення їхньої здатності формувати біоплівки та продукувати фактори вірулентності. Отже, потрібна речовина, що атакуватиме конкретний білок, необхідний бактерії для формування біоплівки, і фактично позбавлятиме бактерію засобів до існування. Бактерія виживе, але сформувати біоплівку вже не зможе, і це саме те, що треба. Такий мікробний препарат буде унікальним, бо він ефективний тільки проти конкретного штаму. В цьому й полягатиме його перевага: він прицільно знищуватиме певний штам, зберігаючи природний мікробіом організму пацієнта. Розробити такий препарат надзвичайно складно, але, на мою думку, за цим – майбутнє.
Альтернативу антибіотикам також можуть скласти бактеріофаги, але у багатьох країнах їхнє застосування зараз заборонене.
– Наскільки вони безпечні?
– Вважається, що безпечні. Теоретично, бактеріофаги мають уражати лише бактерії (бо це віруси бактерій), а для людини вони нейтральні. Але хоч про них відомо вже понад 100 років, та ці віруси все ще малодосліджені. Тому зараз їхнє медичне застосування дозволено тільки в Грузії, а агропромислове – у США. З іншого боку, вони справді ефективні проти бактерій і можуть слугувати платформою для їхнього таргетного знищення. Чому вони не впроваджуються? З різних причин. Можливо, через незацікавленість виробників антибіотиків. Адже антибіотики все ще діють і дають прибутки. Проте водночас вони зумовлюють резистентність бактерій, і з цим потрібно щось робити. Наприклад, якщо вдаватися до таргетної терапії на основі реакції «антиген–антитіло», то наноматеріал (або інший матеріал) можна функціоналізувати за допомогою різних антимікробних сполук, а серед них – і антибіотиками. Тобто класичний антибіотик можна застосувати так, щоб він убивав не весь мікробіом організму, а виключно патоген. До речі, передбачається, що такі функціоналізовані матеріали можна буде і застосовувати перорально або внутрішньовенно, і наносити їх на шкіру (у вигляді крему). Адже поверхню нашого тіла теж заселяють бактерії, зокрема різні види стафілококів: наприклад, Staphylococcus epidermidis і Staphylococcus hominis, які є частиною нашого природного мікробіому й утворюють щось подібне до живого бар’єру на шкірі; але також і Staphylococcus aureus, тобто патогенний золотистий стафілокок. Це надзвичайно цікавий напрям досліджень. А особисто я прагну долучитися до створення інноваційних наноматеріалів для таргетного знищення респіраторних патогенів безпосередньо у легенях. Саме ця ідея лягла в основу мого проєкту, який я подала на конкурс стипендіальної програми «Дії Марії Склодовської-Кюрі», щоб продовжити наукову діяльність у дослідницькій групі професора Цанова.
– А чи не може з цими новими засобами статися та сама біда, що й з антибіотиками? Тобто звикання й вироблення опірності.
– Так, резистентність у бактерій виникає завжди. Навіть до вірусів-бактеріофагів. Але важливо враховувати, що бактерія може набути резистентності саме до антимікробної сполуки, якою буде функціоналізовано матеріал. Водночас білок, відповідальний за формування біоплівки, залишатиметься незмінним. Тому ключове завдання у цьому випадку – не знищити бактерію, а заблокувати її здатність до утворення біоплівки. Бактерія залишиться життєздатною, однак це вже не критично, адже основну загрозу становить саме біоплівка — структурована спільнота мікроорганізмів, яка надзвичайно стійка до антибіотиків і є важливим чинником патогенності. Формування біоплівок — це захисна стратегія бактерій у відповідь на стресові або несприятливі умови. Вони не лише сприяють колонізації господаря, а й забезпечують тривале утримання збудника в його організмі.
Отже, навіть якщо бактерія стане резистентною до певної антимікробної сполуки, то наш метод боротьби все одно лишається придатним, платформа для таргетної терапії не зміниться. Просто якщо одна сполука перестане діяти, треба пробувати інші. Практикують навіть застосування срібла й інших металів у безпечних дозах.
До речі, антибіотикорезистентність бактерій – це проблема не тільки медична, а й аграрна і економічна. Уже згаданий мій проєкт, пов’язаний із біопестицидами, з’явився не на порожньому місці. Це своєрідна синергія з проєктом VINNY. Моя іспанська лабораторія під керівництвом професора Цанко Цанова розробляє нанобіопестициди і нанобіодобрива у консорціумі з 20-ма партнерами (зокрема з Бельгії, Іспанії, Португалії, Італії та Франції) за кошти програми «Горизонт Європа». Цей масштабний проєкт VINNY, розрахований на чотири роки, присвячено проблемам європейських виноградників. Його фінансує Європейський Союз – у межах програми «Горизонт Європа» через ініціативу PRIMA (Partnership for Research and Innovation in the Mediterranean Area). У чому полягають проблеми? Клімат змінюється, температура зростає – і патогенні мікроорганізми у відповідь на ці зміни, починають активніше розвиватися. Зокрема, розвиваються небезпечніші та стійкіші бактерії, бо зазвичай бактерії, які є більш стійкими до певних екстремальних чинників, одночасно більш патогенні. Це не завжди так, тобто ці бактерії можуть бути екологічно безпечними, але може існувати зв’язок між генами, що відповідають за резистентність до металів, і генами, відповідальними за резистентність до антибіотиків. Мета проєкту – розробити нанобіопестициди для боротьби з патогенами виноградників. Проєкт не лише міжнародний, а й міждисциплінарний: його виконують хіміки, біологи, біотехнологи.
Олеся Гаврилюк виступає на звітній зустрічі за проєктом VINNY в Турині (Італія). Січень 2025 року. Фото – з особистого архіву Олесі Гаврилюк

Олеся Гаврилюк і Цанко Цанов у м. Турс (Франція) на звітній зустрічі за проєктом VINNY. Липень 2025 року. Фото – з вебсайту проєкту: projectvinny.eu

Олеся Гаврилюк серед учасників липневої зустрічі виконавців проєкту VINNY. Фото: projectvinny.eu

Цанко Цанов, Олеся Гаврилюк і Йована Богдановіч серед учасників липневої зустрічі виконавців проєкту VINNY. Фото – з особистого архіву Олесі Гаврилюк
Взагалі біологи зараз уже не можуть дозволити собі бути тільки біологами і працювати тільки з іншими біологами. Тепер поєднання різних галузей – це найбільш виграшний і перспективний шлях. Як свідчить практика, міждисциплінарні проєкти і значно успішніші з погляду результатів, і мають вищі шанси здобути фінансування. Наприклад, бакалаврат я закінчила у галузі екологічної біотехнології, магістратуру – з фармацевтичної біотехнології, а магістерську роботу виконувала як біотехнолог. В Україні працюю у відділі біології екстремофільних організмів, в Іспанії – у відділі хімічної інженерії. А різнобічна підготовка і діяльність теж додає балів претендентам на ґранти. Такий тренд. Готуючи заявку на ґрант від програми «Дії Марії Склодовської-Кюрі», щоб почати працювати над наноструктурами для таргетного знешкодження респіраторних патогенів, я вказала не тільки те, що маю біологічний/мікробіологічний фах, а й те, що працюю під керівництвом хімічного технолога у відділі хімічної інженерії, де розробили чимало нанотехнологій і наноматеріалів, зокрема наночастинки, до яких можна додавати різні антимікробні сполуки, перетворюючи їх на функціоналізовані наночастинки. Гадаю, це теж допомогло мені виграти.

На конгресі FEBS у Стамбулі. Презентація результатів проєкту VINNY. Фото: projectvinny.eu
– В Інституті мікробіології і вірусології ім. Д.К. Заболотного НАН України Ви від 2023 року очолюєте Раду молодих вчених. Що вже зроблено? Що плануєте? Які пріоритети?
– Наша найперша функція зараз – інформувати колег про конкурсні програми і наукові заходи. Наприклад, торік у Мілані відбувся черговий конгрес Федерації європейських біохімічних товариств. І там надзвичайно багато говорили про нові можливості, особливо для молоді. Всім, що бачу, ділюся з колегами. Радію, що багатьом ця інформація стає в пригоді.
По-друге, щороку наша Рада проводить інститутську молодіжну наукову конференцію. Торік захід відбувся у листопаді, організацією опікувалася Марічка Златогурська [кандидатка біологічних наук, наукова співробітниця відділу молекулярної генетики бактеріофагів]. Вона, до речі, теж нещодавно отримала ґрант від програми «Дії Марії Склодовської-Кюрі» – на стажування в Чехії. Близько 80% учасників конференції – науковці нашого ж Інституту, але плануємо розширюватись і залучати більше студентів і аспірантів та молодих науковців з інших установ. Можливо, об’єднаємо зусилля зі ще одним інститутом Академії. Головна наша мета – створити простір для знайомства, обміну думками і налагодження зв’язків між молодими дослідниками. Ми не проводимо конференцію заради самої конференції – у підсумку має виникати нова співпраця. Крім того, ми сподіваємося, що учасники-студенти, ознайомившись із нашим Інститутом, вступлять до нас в аспірантуру, бо молодих науковців завжди бракує – як в Україні, так і за кордоном. І вони скрізь потрібні. Наприклад, у нашому відділі зараз працюють студенти з Київського національного університету імені Тараса Шевченка і Державного університету «Київський авіаційний інститут». Запрошуємо всіх. Так, значна частина з них після закінчення магістерської роботи або після аспірантури піде шукати щастя деінде. Але дехто й залишиться. А навіть і з тими, хто піде, теж не варто втрачати зв’язків. Ми всі потрібні і можемо бути корисні одне одному.

Афіша торішньої молодіжної наукової конференції в Інституті мікробіології і вірусології ім. Д.К. Заболотного НАН України. Джерело: сайт Інституту (imv.org.ua)
По-третє, намагаємося залучати інших молодих колег у наші наукові проєкти. А крім того, якщо хтось із членів Ради перебуває на стажуванні за кордоном, то він чи вона завжди готові допомогти зорієнтуватися на місці тим, хто здобув тревел-ґрант на наукову подорож до тієї ж країни.
Тобто головна роль нашої Ради – інформаційно-організаційна.

Олеся Гаврилюк доповідає про результати роботи Ради молодих вчених Інституту мікробіології і вірусології ім. Д.К. Заболотного НАН України у 2024 році. Фото – з Facebook-сторінки науковиці

У відділі біології екстремофільних мікроорганізмів. Фото пресслужби НАН України
– Пані Олесю, ми вже частково торкнулися цього питання, але. Що можете порадити дітям, які тільки-но починають свій шлях у науку? Розкажіть, будь ласка, також про свій досвід у Малій академії наук.
– Я щиро рада, що колись не послухала порад піти працювати у фармацевтичну компанію чи на підприємство одразу після закінчення університету, хоча це й могло б означати стабільніший дохід і, можливо, вищу зарплату. Мені не раз казали, що «наука — це для бідних», що краще шукати «нормальну» роботу, навіть деякі близькі мені люди наполягали на цьому. Але я обрала інший шлях і жодного разу не пошкодувала. Моя порада — не слухати нікого, хто сумнівається у ваших мріях. Вирішувати варто серцем, бо тільки тоді ви будете по-справжньому щасливі у тому, що робите.
Щодо Малої академії наук: так, це класний початок, якщо дитина всерйоз зацікавлена. Зазвичай у МАН обирали одну секцію, але я відвідувала одночасно дві – біологічну й історичну. Було багато цікавих подій. А зараз з’явилося ще більше можливостей для школярів, зокрема поїздки на олімпіади і навіть на конференції за кордон.
Головна моя порада – не здаватися, коли щось не виходить з першого разу. Ким би ви не були – школярем, студентом, аспірантом, молодим науковцем. Не кожен, хто бере участь у змаганні, виграє, проте це не значить, що змагання зовсім не варте вашої участі. Це стосується як шкільних олімпіад, так і ґрантових конкурсів. Буває, подаєш 5 заявок – і отримуєш 5 відмов. Звісно, це засмучує і пригнічує. Іноді люди здаються, перестають боротися. В таких ситуаціях нагадуйте собі, що якщо ви здастеся, то краще точно не стане. Але коли ви змагаєтеся, то шанс на успіх завжди є. У будь-якому разі здобудете корисний досвід. Те саме, до речі, і з науковими статтями: не все гладенько, не кожен текст беруть у друк із першої спроби. Науковцем взагалі бути важко. Але і надзвичайно захопливо.
Наукова спільнота – це особливе середовище, особлива атмосфера, особливі люди. Наприклад, у вересні минулого року я була у Хорватії на дев’ятиденній літній школі для постдоків від Федерації європейських мікробіологічних товариств. Тематика стосувалася впливу кліматичних змін на функціонування мікроорганізмів і на мікробні угруповання, на безпечність харчових продуктів і води, водних середовищ. Я очікувала, що лекції будуть більш формальними, що ми просто прослухаємо важливий матеріал – та й по всьому. Але реальність приємно здивувала. Школою керували професори Андрея Райкович (Andreja Rajkovic) із Бельгії та Ліза Стейн (Lisa Stein) із Канади. Обоє вони – справжні «монстри» у своїй справі, дуже високоцитовані науковці, а водночас дуже відкриті і доброзичливі люди, які залюбки ділилися з нами порадами і залишили свої контакти. Ми зберегли добрі робочі взаємини, і я завжди можу звернутися за порадою. З іншими постдоками, які були на цій школі, теж продовжую спілкуватися. Обмінюємося інформацією. Отак для мене виглядає ідеальна комунікація у науці.

На літній школі для постдоків у Хорватії. Фото – з Facebook-сторінки Федерації європейських мікробіологічних товариств

Олеся Гаврилюк із наставниками учасників торішньої літньої школи для постдоків від Федерації європейських мікробіологічних товариств: ліворуч — Андрея Райкович, праворуч – Ліза Стейн і Васо Талеські (директори школи). Фото – з особистого архіву науковиці
Нещодавно, у середині липня, я взяла участь у черговому конгресі, організованому Федерацією європейських мікробіологічних товариств (FEMS). На конгресі мені пощастило зустріти колег-постдоків, з якими ми разом брали участь у літній школі від FEMS, що відбулася торік у Хорватії. Одним із приємних моментів було побачити Васо Талеські — директора школи, який працював у тандемі з Лізою та Андрея. Ми були щиро раді можливості поспілкуватися, і я була приємно вражена, що він нас пам’ятає. Разом із колегами Марією Лободою та Нурі Інфанте ми провели інтерактивну сесію під назвою «Мікробні детективи: застосування мікробної криміналістики у реальних розслідуваннях». Нурі — ще одна моя подруга і колега, але в іспанській лабораторії. Хоча ми працюємо в різних наукових групах, нас об’єднують спільні інтереси, адже обидві ми мікробіологи серед хімічних інженерів. Ми обговорювали справжні випадки біотероризму та демонстрували, як мікробіологія — зокрема, сучасні омікс-технології — може допомогти у розкритті злочинів проти людства. Сесія проходила у форматі роботи в групах, учасники «приміряли на себе» роль мікробних детективів. Загалом у заході взяли участь понад 200 осіб, і навіть Васо Талеські завітав послухати наш виступ — це було надзвичайно надихаюче і важливе визнання.

Олеся Гаврилюк, Марія Лобода і Нурі Інфанте виступають на інтерактивній сесії «Мікробні детективи: застосування мікробної криміналістики у реальних розслідуваннях». Фото: projectvinny.eu

Триває «детективна» сесія FEMS. Фото: projectvinny.eu

На конгресі FEMS: Олеся Гаврилюк з керівником напряму заходів і міжнародної співпраці у FEMS, директором літньої школи постдоків FEMS професором, доктором Васо Талеські (Мілан, липень 2025 року)
Крім того, Каріанна Бурмаєр (Carianne Buurmeijer) — ще одна з організаторів FEMS, з якою ми познайомилися під час школи для постдоків, — залучила випускників до модерування сесій. Це дало змогу відчути себе частиною великої наукової спільноти, відчути атмосферу підтримки, обміну досвідом і натхнення.

Під час модерації доповідей учасників конгресу FEMS (Мілан, липень 2025 року). Фото: projectvinny.eu

Там само
– Чи важко бути науковицею в Україні? А за кордоном?
– Особисто я, на щастя, не стикалася з дискримінацією, чи аб’юзом, чи будь-яким неналежним ставленням через те, що я жінка. У нашому відділі в Інституті мікробіології і вірусології взагалі абсолютна більшість працівників – це жінки. Але знаю, що часто буває й інакше. На заходах за кордоном я перетиналася з вірменками й італійками, які розповідали, що чоловіків-науковців у їхніх країнах сприймають серйозніше і ті мають більше кар’єрних перспектив. Чоловіків більше і у нашій науковій групі в Іспанії. Я помітила, що на Заході жінки у природничих науках і математиці – у меншості. Крім того, у багатьох країнах керівні посади в науці займають здебільшого чоловіки. Гадаю, науковиці стають більш вразливими у професії та кар’єрі, коли вирішують народити дитину. За три роки декретної відпустки, як це передбачено, наприклад, в Україні, можна суттєво відстати професійно. В Іспанії ж діє система спеціальних закладів для немовлят (аналог колишніх ясел), і жінка може повернутися до роботи вже через пів року після пологів.
Наприклад, одна з наших колег із лабораторії вийшла на роботу вже через три місяці після народження дитини. Перші три місяці з малюком була вона, наступні — її чоловік, після чого дитину влаштували до садочка. Так, труднощі були — хвороби, адаптація, особливо в перший рік. Але загалом система там зручна, добре продумана й організована. Очевидно, жінкам у науці справді доводиться складніше. Але я б не сказала, що ситуація критична. Багато залежить від самої людини, її рішучості й віри у власну справу. Треба просто робити те, що любиш. Взагалі підтримка жінок – особливий складник сучасної наукової політики. Жінкам-науковицям допомагають розвиватися і залишатися в науці. Наприклад, у межах багатьох міжнародних програм («Горизонт Європа», «Дії Марії Склодовської-Кюрі») передбачено індикатори ґендерної рівності та пріоритет жінок на рівних умовах.

За лаштунками і на сцені церемонії нагородження українською премією L'Oréal-UNESCO «Для жінок у науці» (Київ, грудень 2024 року). Автор фото праворуч – Віталій Ухов. Фото ліворуч – з Facebook-сторінки Олесі Гаврилюк
Особисто мене дуже надихнула відзнака від журі премії «Для жінок у науці». І, звісно, було надзвичайно приємно бути присутньою на церемонії нагородження. Це додає впевненості й віри в те, що твоя праця не залишається непоміченою і справді має значення. Хоч я і не стала головною лауреаткою, бути відзначеною серед такої кількості талановитих жінок — це велика честь. Після заходу з’явилося ще більше мотивації працювати далі та ділитися досвідом із молодшими колегами. Ми, жінки в науці, маємо підтримувати одна одну, об’єднуватися, створювати мережі співпраці.
Спілкувалася Сніжана Мазуренко